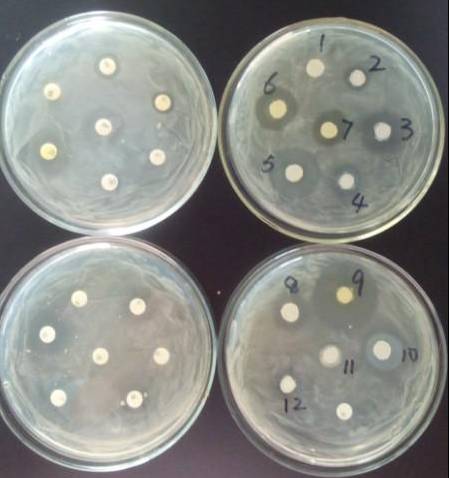
药敏试验方法及操作规程!

5 年
手机商铺
公司新闻/正文
870 人阅读发布时间:2023-03-17 14:27
1、快速药敏试验:采取病料后直接涂布进行药敏试验,与病原菌分离同时进行,可根据药敏结果初步进行治疗。此种方法适用于发病初期病料组织,8-16小时可快速出具检测结果。
2、前增菌培养法药敏试验:前增菌培养法耗时略长,需要2-3天的时间,先对细菌增菌培养后再进行药敏试验。此种方法可避免快速药敏试验由于无细菌生长或细菌生长较少、抑菌圈不明显等而导致不能及时读取结果的情况出现。
3、传统法药敏试验:传统法耗时较长,需要3-4天的时间,对于一般养殖场定期监测病原菌及其敏感性时可以使用此方法。能较好地分离出病原菌,病原菌经纯培养后,进行药敏试验,得出的数据可以准确反应出病原菌对某一药物的敏感性。

(1)样品处理:用烧灼的灭菌刀片烫灼组织表面杂菌,无菌操作用剪刀剪取组织,置于灭菌平皿中,滴加适量生理盐水,剪碎并混匀组织,呈糊状最佳。
(2) 涂板:用灭菌棉签沾取病料组织混悬液,均匀涂抹于营养琼脂平板上,反复2次,每次将平板旋转60度,最后沿周边绕两圈,确保涂抹均匀。
(3) 贴药敏纸片及培养:用镊子夹取药敏纸片平放在琼脂平板上,并轻压使紧贴于琼脂平板表面,药敏纸片一旦接触培养基表面不要再移动。在培养基中央贴一片,外周以等距离贴若干种纸片,一个平板(直径90毫米)可贴6-7个抗菌药敏片,并标记每个药敏片的药名。贴好纸片的平板于37℃培养16-24小时观察结果。
(1) 样品处理:用灭菌棉签沾取组织内部,然后打开装有增菌液(营养肉汤)的试管,使棉签与增菌液混合,反复挤压5次,取出棉签过火焰烧灼灭菌弃掉。试管口和试管塞过火焰灭菌,盖上试管塞,做好标记,放入恒温箱中37℃培养12-24小时,此肉汤菌液为前增菌液。
(2) 涂板:用灭菌棉签沾取前增菌液或稀释后增菌液,在管壁轻碰几下,挤掉多余水分,均匀涂抹于营养琼脂平板上,反复2次,每次将平板旋转60度,最后沿周边绕两圈,保证涂均匀。
(3) 贴药敏纸片及培养:用镊子夹取药敏纸片平放在琼脂平板上,并轻压使紧贴于琼脂平板表面,药敏纸片一旦接触培养基表面不要再移动。在培养基中央贴一片,外周以等距离贴若干种纸片,一个平板(直径90毫米)可贴6-7个抗菌药敏片,并标记每个药敏片的药名。贴好纸片的平板于37℃培养16-24小时观察结果。
(1) 样品处理:用烧灼的灭菌剪刀烫灼组织表面杂菌,用剪刀在病料组织中剪开一切口,用棉签或接种环沾取组织病料,进行细菌分离,培养16-18小时后挑取接种平皿中菌落,置于无菌1.5ml离心管中,滴加500ul生理盐水,混匀菌落。注意同时对分离细菌和进行药敏实验菌落进行染色,确定为同种致病菌。
(2) 涂板:用灭菌棉签沾取菌落混悬液,均匀涂抹于营养琼脂平板上,反复2次,每次将平板旋转60度,最后沿周边绕两圈,保证涂均匀。
(3) 贴药敏纸片及培养:用镊子夹取药敏纸片平放在琼脂平板上,并轻压使紧贴于琼脂平板表面,药敏纸片一旦接触培养基表面不要再移动。在培养基中央贴一片,外周以等距离贴若干种纸片,一个平板(直径90毫米)可贴6-7个抗菌药敏片,并标记每个药敏片的药名。贴好纸片的平板于37℃培养16-24小时观察结果。
1、说明:经培养后,凡对涂布的细菌有抑制能力的抗菌药物,在其纸片四周出现一个无菌生长的圆圈,称为抑菌圈。可用直尺测量其抑菌圈的大小,抑菌圈越大,说明该菌对此种药物敏感性越大,反之越小。若无抑菌圈,则说明该菌对此药具有耐药性。
2、判定标准:根据《抗微生物药物敏感性试验执行标准2010》中的判断标准进行判断,对于商品药物,抑菌圈直径>20mm为极敏,15-20mm为高敏,10-14mm为中敏,<10mm为低敏,0为耐药。
3、注意事项
(1)制备纸片的滤纸要求吸水性好,均匀不含无关的化学物质或色素。
(2)干燥的药敏纸片必须在密封,放有干燥剂的容器中存放,以防受潮。
(3)药敏纸片制备后立即用敏感细菌作药敏试验,并记录其抑菌圈,每月复查一次。
(4)培养基要求是适合常见致病菌生长,不含被试药物的拮抗剂。
(5)培养基厚度对抑菌圈大小有直接影响,要求3-4mm厚的平板。
(6)培养基PH值对某些药物抑菌区影响很大,一般PH应为7.2-7.4。

说明:转载只为分享目的,如有侵权请联系删除,谢谢!